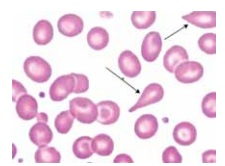
Enunciado 4691530-1

Foram encontradas 1.045 questões.
Em relação aos diferentes tipos de fixação das lâminas,
é correto afirmar que
Provas
Questão presente nas seguintes provas
Assinale a alternativa que relaciona corretamente o tipo
de amostra e sua coleta.
Provas
Questão presente nas seguintes provas
A descalcificação de materiais ósseos deve ser feita
colocando-se os fragmentos em
Provas
Questão presente nas seguintes provas
A técnica histológica de rotina consiste em uma série
de etapas com o objetivo de preparar determinado tecido,
a fim de que sejam analisados microscopicamente. A
ordem em que esses procedimentos devem ser realizados, após a coleta de material, é:
Provas
Questão presente nas seguintes provas
Assinale a alternativa que apresenta, entre outras, as
referências obrigatórias em um laudo macroscópico de
espécimes examinados.
Provas
Questão presente nas seguintes provas
Na biologia molecular, para avaliar amostras de RNA pela
técnica de PCR (Polymerase Chain Reaction), é necessário realizar uma etapa adicional chamada:
Provas
Questão presente nas seguintes provas
Paciente de 47 anos chega ao pronto atendimento com
queixas de dificuldade respiratória, confusão mental e
sensação de mal-estar geral. Ao exame físico, apresenta cianose periférica, frequência respiratória aumentada
e saturação de oxigênio de 85% no oxímetro. Qual é o
exame laboratorial mais indicado para avaliar a condição
respiratória e o estado ácido básico desse paciente?
Provas
Questão presente nas seguintes provas
Analise a imagem.
Material: Esfregaço periférico
 (Imagem gentilmente cedida pelo Laboratório de Análises Clínicas do
Centro Universitário FMABC)
(Imagem gentilmente cedida pelo Laboratório de Análises Clínicas do
Centro Universitário FMABC)
O esfregaço de sangue venoso revela qual tipo de poiquilocitose sinalizada pelas setas?
(Imagem gentilmente cedida pelo Laboratório de Análises Clínicas do
Centro Universitário FMABC)
(Imagem gentilmente cedida pelo Laboratório de Análises Clínicas do
Centro Universitário FMABC)
O esfregaço de sangue venoso revela qual tipo de poiquilocitose sinalizada pelas setas?
Provas
Questão presente nas seguintes provas
Os testes rápidos padrão para Zika vírus disponíveis no
mercado detectam as imunoglobulinas:
Provas
Questão presente nas seguintes provas
Sobre os manuais de biossegurança nos laboratórios
clínicos, a responsabilidade pertence:
Provas
Questão presente nas seguintes provas
Cadernos
Caderno Container